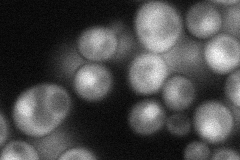
YIL017C
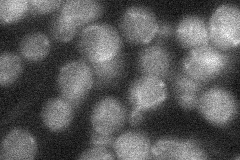
YIL017C
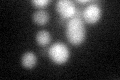
YIL017C

View description
Protein involved in proteasome-dependent catabolite degradation of fructose-1,6-bisphosphatase (FBPase); localized to the nucleus and the cytoplasm
Localization:
Intensity:
Fold change:
Significance:
-
C’ GFP library in SD

cytosol19.48 -
N' NOP1pr-GFP in SD
cytosol,nucleus63.3222 -
N' TEF2pr-mCherry in SD

nucleus31.1248 -
N' NATIVEpr-GFP in SD
below threshold21.837 -
N' TEF2pr-VC and Cyto-VN in SD

cytosol31.2815 -
C’ GFP library in SD+DTT
cytosol20.261.03No -
C’ GFP library in SD+H2O2

cytosol19.691.01No -
C’ GFP library in Starvation Media

cytosol19.981.02No -
C’ GFP library on the background of Pup2-DaMP

cytosol -
C’ GFP library on the background of CCT mutant

cytosol21.1631.08566No
